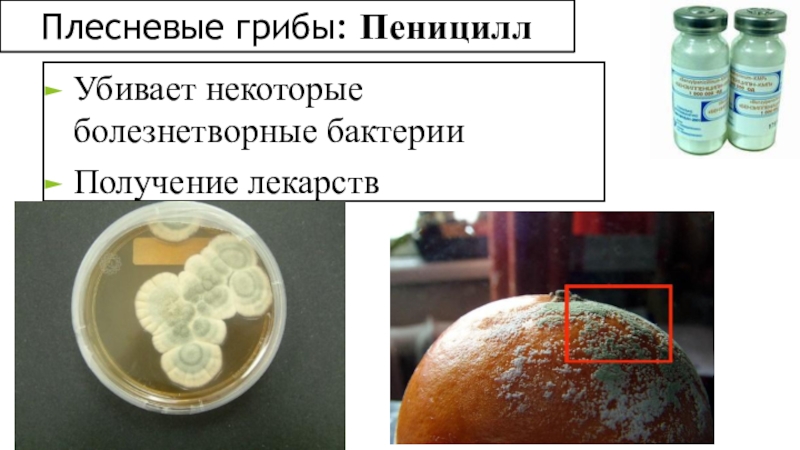

- Главная
- Разное
- Образование
- Спорт
- Естествознание
- Природоведение
- Религиоведение
- Французский язык
- Черчение
- Английский язык
- Астрономия
- Алгебра
- Биология
- География
- Геометрия
- Детские презентации
- Информатика
- История
- Литература
- Математика
- Музыка
- МХК
- Немецкий язык
- ОБЖ
- Обществознание
- Окружающий мир
- Педагогика
- Русский язык
- Технология
- Физика
- Философия
- Химия
- Шаблоны, фоны, картинки для презентаций
- Экология
- Экономика
Презентация, доклад по биологии на тему Грибы
Содержание
- 1. Презентация по биологии на тему Грибы
- 2. Грибы – особое царство живой природы, объединяющее
- 3. Строение шляпочного гриба
- 4. Обитание грибов:ПочваВодаЖилищаПищевые продуктыТело человекаТело животных
- 5. Питание грибовКак животные грибы питаются готовыми органическими веществамиКак растениягрибы поглощают пищу путём всасывания
- 6. По способу питания грибы различают как: Паразиты
- 7. Размножение грибовГрибница образуется в результате слияния специализированных
- 8. Роль грибов в природе и жизни человека
- 9. Симбиоз грибов и растений
- 10. Съедобные грибы
- 11. Ядовитые грибы
- 12. Плесневые грибы: МУКОР
- 13. Плесневые грибы: ПенициллУбивает некоторые болезнетворные бактерииПолучение лекарств
- 14. ДрожжиПриготовление хлеба
- 15. Грибы- ПАРАЗИТЫ (трутовик)
- 16. Слайд 16
Грибы – особое царство живой природы, объединяющее (эукариотические) организмы, сочетающие в себе некоторые признаки как растений, так и животных.
Слайд 2Грибы – особое царство живой природы, объединяющее (эукариотические) организмы, сочетающие в
себе некоторые признаки как растений, так и животных.
Слайд 5Питание грибов
Как животные
грибы питаются готовыми органическими веществами
Как растения
грибы поглощают пищу
путём всасывания
Слайд 6По способу питания грибы различают как:
Паразиты
Поселяются на живых организмах
и питаются за их счёт
Сапрофиты
Питаются мёртвыми
органическими веществами
Слайд 7Размножение грибов
Грибница образуется в результате слияния специализированных половых клеток
бесполое
половое
С помощью спец.клеток-
спор или вегетативно (т.е. частями грибницы или почкованием)